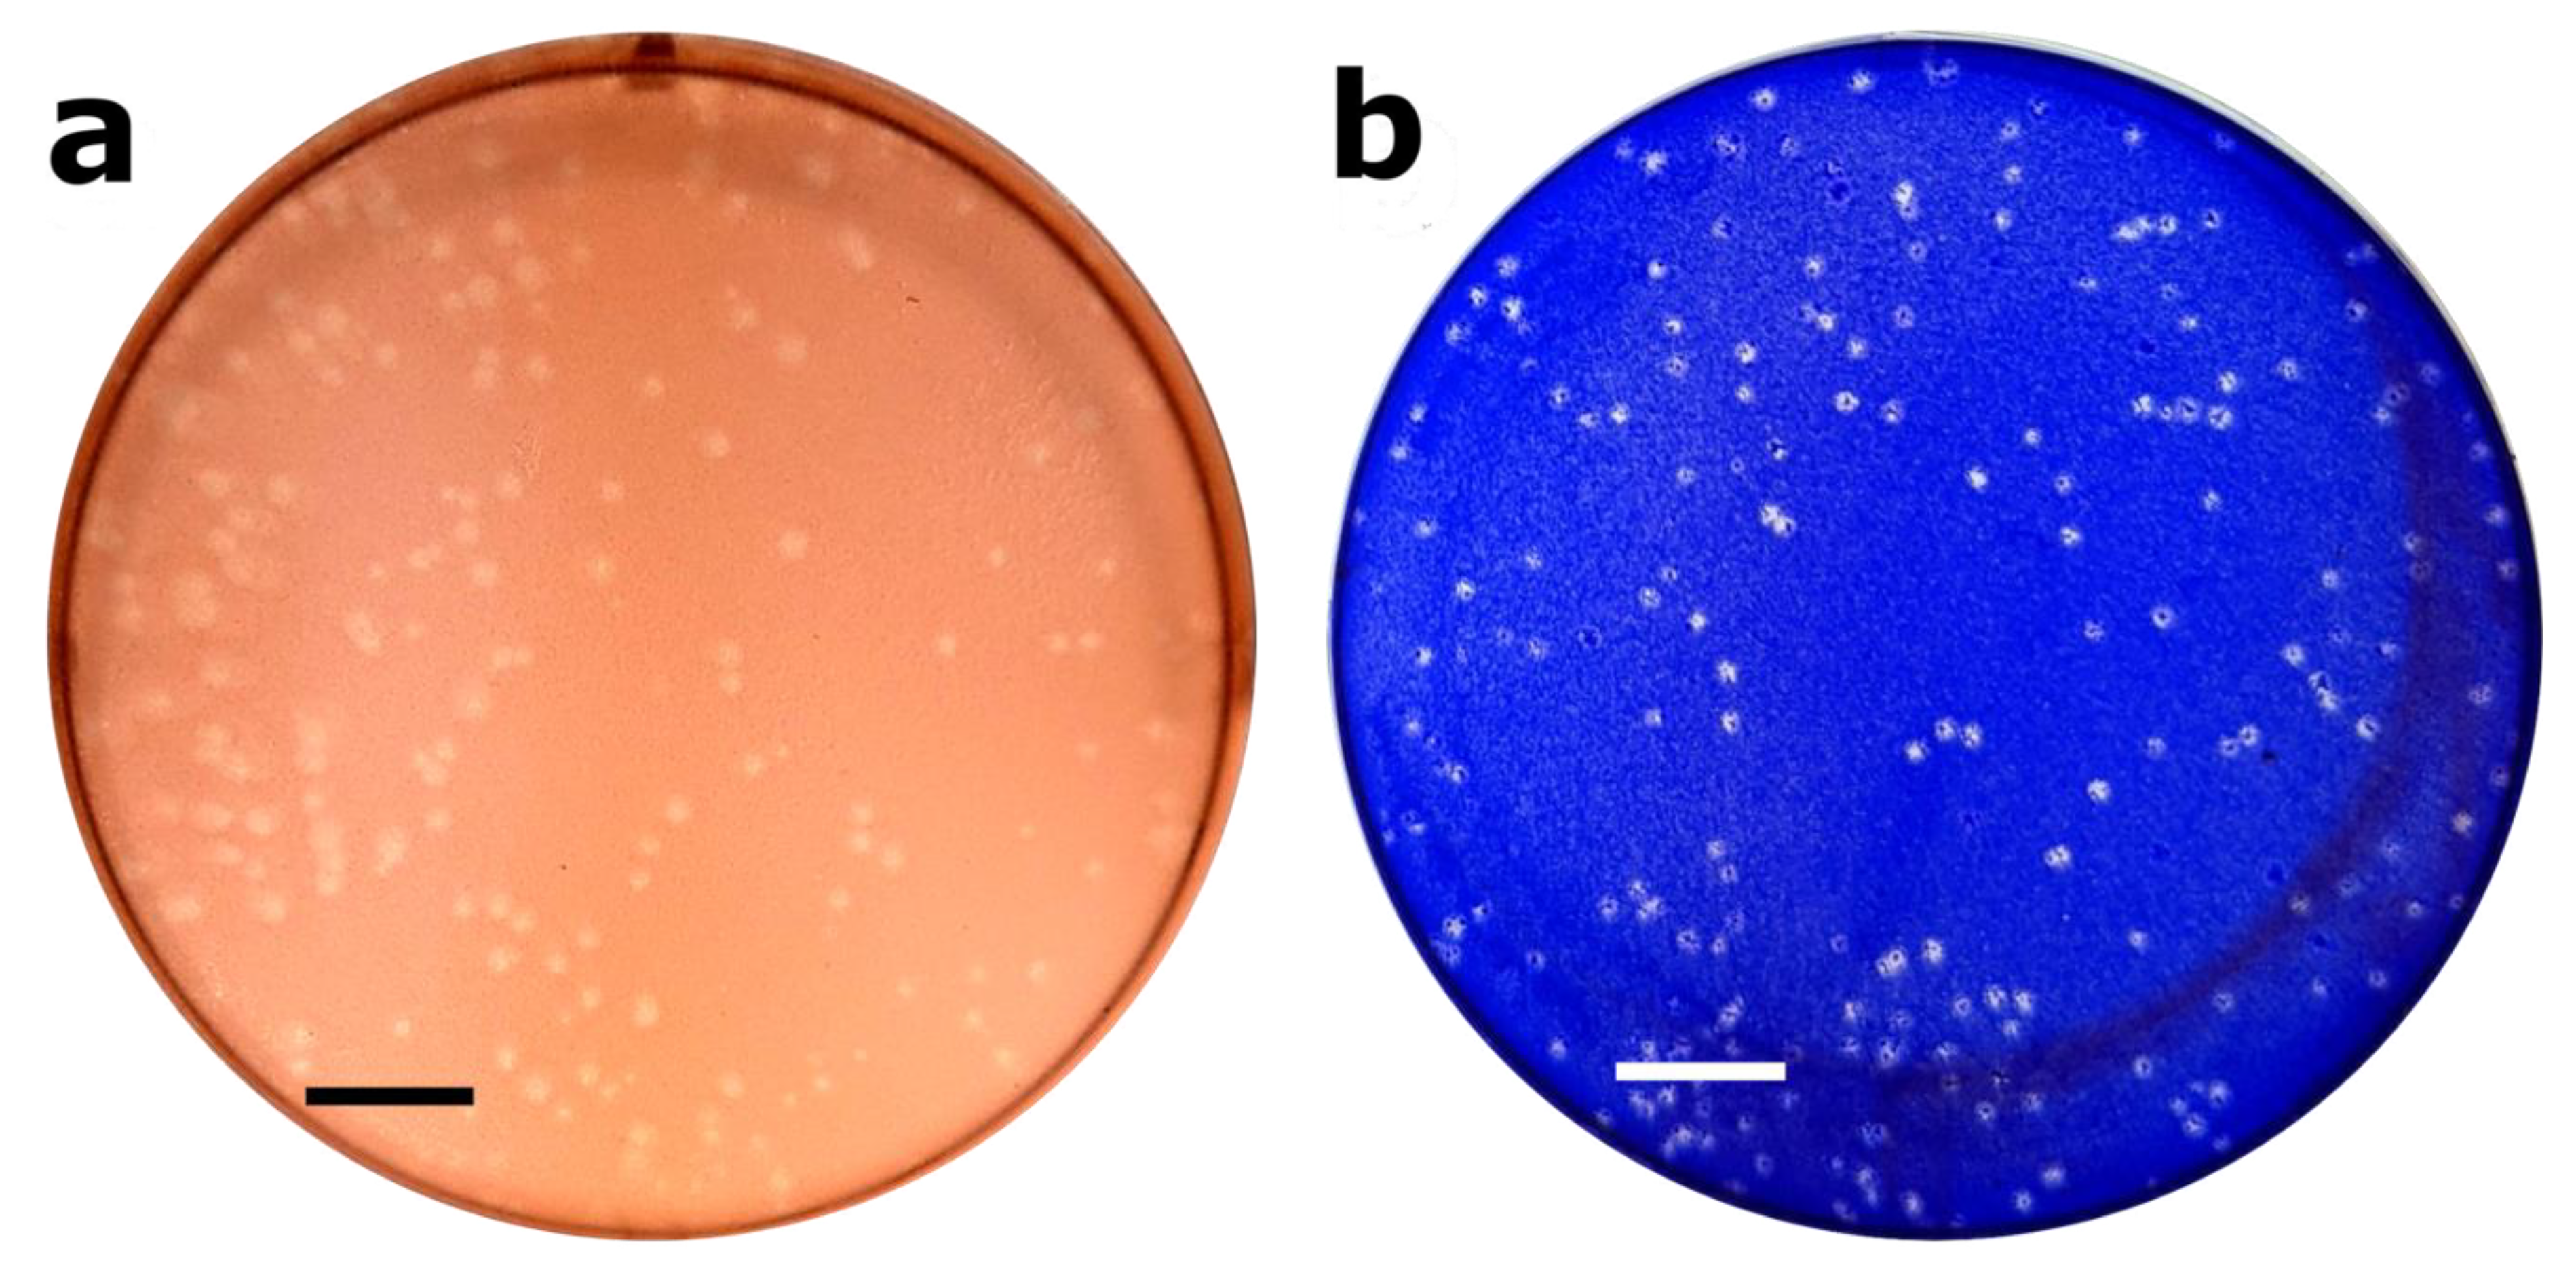
Mps 05 00005 g003

Optimized Protocols for the Propagation and Quantification of Infectious Murine Hepatitis Virus (MHV-A59) Using NCTC Clone 1469 and 929 Cells
Abstract
:1. Introduction
2. Experimental Design
2.1. Materials
- 2 mL Internal Threaded Polypropylene Cryogenic Vial (Corning, NY, USA; Cat. No.: 431386)
- 2-Propanol, Certified ACS (Fisher Chemical, Fairlawn, NJ, USA; Cat. No.: A416-1)
- 0.2 mL Polypropylene PCR 8-Tube Strips (USA Scientific, Ocala, FL; Cat. No.: 14024700)
- 15 mL Polypropylene Centrifuge Tubes (Celltreat, Pepperell, MA, USA; Cat. No.: 229412)
- 50 mL Polypropylene Centrifuge Tubes (Celltreat, Pepperell, MA, USA; Cat. No.: 229420)
- Crystal Violet, 1% aqueous solution (Sigma-Aldrich, St. Louis, MO, USA; Cat. No.: V5265)
- Dimethyl sulfoxide, ≥99.5% (GC) (Sigma-Aldrich, St. Louis, MO, USA; Cat. No.: D4540)
- Dulbecco’s Modification of Eagle’s Medium, Powder (Corning, Manassas, VA, USA; Cat. No.: 50003-PB)
- 500 mL Disposable Polyethersulfone (PES) 0.20 μm Filter Units (Fisher Scientific, Rochester, NY, USA; Cat. No.: FB12566504)
- 6-Well Surface-Treated Sterile Tissue Culture Plates (Fisher Scientific, Rochester, NY, USA; Cat. No.: FB012927)
- Formaldehyde, 37% by Weight/Molecular Biology (Fisher BioReagents, Fair Lawn, NJ, USA; Cat. No.: BP531-500)
- Horse Serum, New Zealand origin, not heat-inactivated (Gibco, Penrose, Auckland, New Zealand; Cat. No.: 16050122)
- Methyl Cellulose, viscosity 4000 cP (Sigma-Aldrich, St. Louis, MO, USA; Cat. No.: M0512)
- Minimum Essential Medium Eagle (EMEM), powder (Sigma-Aldrich, St. Louis, MO, USA; Cat. No.: M0643)
- Murine Hepatitis Virus (MHV-A59) (ATCC, Manassas, VA, USA; Cat. No.: VR-764)
- NCTC 135 Medium (Sigma-Aldrich, St. Louis, MO, USA; Cat. No.: N3262)
- NCTC Clone 1469 [derivative of NCTC 721] (ATCC, Manassas, VA, USA; Cat. No.: CCL-9.1)
- NCTC Clone 929 [L cell, L-929, derivative of Strain L] (ATCC, Manassas, VA, USA; Cat. No.: CCL-1)
- Neutral Red, 50% min. dye content (ACROS Organics, NJ, USA; Cat. No.: 229811000)
- 25 cm2 Nunc™ EasYFlask™ Cell Culture Flasks (Thermo Scientific, Newington, NH, USA; Cat. No.: 156340)
- 75 cm2 Nunc™ EasYFlask™ Cell Culture Flasks (Thermo Scientific, Newington, NH, USA; Cat. No.: 156499)
- Phosphate-Buffered Saline (PBS), pH 7.2 (Gibco, Grand Island, NY, USA; Cat. No.: 20012027)
- Penicillin-Streptomycin-Glutamine (100×), 10,000 U/mL (Gibco, Grand Island, NY, USA; Cat. No.: 10378016)
- SeaPlaque™ Agarose (Lonza, Rockland, ME, USA; Cat. No.: 50100)
- Sodium Bicarbonate, 7.5% solution (Gibco, Grand Island, NY, USA; Cat. No.: 25080-094)
- Sodium Pyruvate Solution, 100 mM (Sigma-Aldrich, St. Louis, MO, USA; Cat. No.: S8636)
- Trypan Blue, 0.4% (w/v) in PBS, pH 7.5 (Corning, Manassas, VA, USA; Cat. No.: 25-900-CI)
- Trypsin-EDTA (0.05%), phenol red (Gibco, Grand Island, NY, USA; Cat. No.: 25300054)
2.2. Equipment
- −80 °C Freezer, Revco™ RLE Series (Thermo Scientific, Newington, NH, USA; Cat. No.: RLE60086A)
- Analytical Balance, Adventurer® Pro (Ohaus, Parsippany, NJ, USA; Cat. No.: AV114)
- Refrigerated Benchtop Centrifuge, Allegra 64R (Beckman Coulter, Indianapolis, IN, USA; Cat. No.: 367586)
- Fixed-Angle Aluminum Rotor, capacity of 6 × 85 mL (Beckman Coulter, Indianapolis, IN, USA; Cat. No.: F0685)
- Biological Safety Cabinet, 1300 Series II, Type A2 (Thermo Scientific, Newington, NH, USA; Cat. No.: 1375)
- Carbon Dioxide (CO2), Industrial Grade (Airgas, Radnor, PA, USA; Cat. No.: CD 50)
- CO2 Incubator, Heracell™ Vios 160i (Thermo Scientific, Newington, NH, USA; Cat. No.: 50144906)
- TC20™ Automated Cell Counter (Bio-Rad, Hercules, CA, USA; Cat. No.: 1450102)
- Cell Counting Slides for TC20™ Cell Counter (Bio-Rad, Hercules, CA, USA; Cat. No.: 1450011)
- Inverted Phase Contrast Microscope, TMS (Nikon, Melville, NY, USA; Cat. No.: TMS 213971)
- Liquid Nitrogen Cryogenic Storage Vessel (Taylor-Wharton, Baytown, TX, USA; Cat. No.: 34XT)
- LSE™ Compact Centrifuge, capacity of 12 × 15 mL (Corning, NY, USA; Cat. No.: 6756)
- Mr. Frosty™ Freezing Container (Thermo Scientific, Newington, NH, USA; Cat. No.: 5100-0001)
- Precision™ General Purpose Water Bath, capacity of 5 L (Thermo Scientific, Newington, NH, USA; Cat. No.: TSGP05)
3. Procedure
3.1. Freeze Stock Revival (72–168 h)
- 1.
- Temper complete media to 37 °C.
- a.
- Complete DMEM for NCTC clone 1469 (Section 5.1.1).
- b.
- Complete EMEM for NCTC clone 929 (Section 5.1.2).
- 2.
- Take out the frozen vial of cells from the liquid nitrogen storage vessel and immediately transfer to a 37 °C water bath.
- a.
CRITICAL STEP—Upon receiving cells from ATCC, they should be immediately stored in the vapor phase of the liquid nitrogen cryogenic storage vessel (−135 °C to −190 °C).
- b.
- Avoid submerging the vial in the water bath to prevent any water from entering inside the vial.
- 3.
- Let the vial almost completely thaw (2–3 min).
- 4.
- In a biosafety cabinet, transfer the vial content into a 15 mL centrifuge tube.
- 5.
- Add 5 mL pre-warmed media dropwise and pipette up and down gently to break clumps.
- 6.
- In a 0.2 mL tube, combine 10 µL of cell suspension with 10 µL of trypan blue and pipette gently to mix. Load the cell counting slide with 10 µL of the mixture then insert into the TC20™ cell counter to enumerate the Total and Live cells.
- a.
- Ensure the slide is clean without any dust or fingerprints.
- b.
CRITICAL STEP—Ensure no air bubbles are trapped in the cell counting slide to obtain an accurate reading.
- 7.
- Seed a 25 cm2 flask with:
- a.
- For NCTC clone 1469: 1.0 × 106 of live cells (the whole suspension may be required).
- i.
- Incubate cells for up to 7 d in a 37 °C incubator, 5% CO2. Since NCTC clone 1469 is composed of a mixed population of cells, there will be a variety of weakly adherent and suspended round cells as well as adherent epithelial-like cells. Cells can be passaged after 3–4 d if the confluency (round, weakly adherent cells plus epithelial-like cells) is >60%. Otherwise, the cell culture medium should be replaced after 3–4 d and the flask incubated until 7 d post revival.
- 1.
- To replace the medium:
- a.
- Collect the old cell culture medium in a 15 mL centrifuge tube.
- b.
- Add 1 mL of fresh medium (tempered to 37 °C) to the flask to prevent any adhered cells from drying out.
- c.
- Centrifuge the old cell culture medium at 300× g (RT) for 5 min to collect the suspended cells.
- d.
- Gently resuspend the pellet in 4 mL of fresh medium and add back to the flask.
- b.
- For NCTC clone 929: 5.0 × 105 of live cells (the whole suspension may be required).
- i.
- Incubate cells for up to 3–4 d in a 37 °C incubator, 5% CO2 until 80–95% confluent.
- 8.
- The total volume of cell suspension and cell culture medium should be ca. 5 mL.
3.2. Cell Passage
3.2.1. NCTC Clone 1469 (48–120 h)
- 1.
- Temper PBS, trypsin, and complete DMEM medium to 37 °C in a water bath.
- 2.
- For each passage, prepare at least two flasks (one flask as a backup).
- 3.
- Once the cells reach appropriate confluency (Figure 1a), remove the culture medium by decanting or pipetting and transfer to a 50 mL centrifuge tube.
- 4.
- While holding the flask at a 45° angle, wash the cell monolayer by gently dispensing PBS (tempered to 37 °C) using a serological pipette to remove any residual serum that will interfere with trypsinization.
- a.
- Recommended volumes: 5 mL PBS for a 25 cm2 flask and 10 mL PBS for a 75 cm2 flask
- b.
CRITICAL STEP—Only wash once and avoid shaking to prevent dislodging too many of the weakly adherent cells. Some NCTC clone 1469 cells will be dislodged, as evidenced by the wash PBS becoming slightly cloudy, but efforts should be made to prevent too many of the cells from being dislodged.
- 5.
- Rotate the flask so that the wash PBS accumulates in the corner opposite the cell monolayer (typically one of the top corners) and remove using the same serological pipette.
- a.
- Discard the PBS wash into the waste container.
- i.
- Bleach the waste container before disposal.
- b.
CRITICAL STEP—Avoid touching the bottom of the flask with the pipette and accidentally scraping off cells.
- 6.
- Add trypsin (tempered to 37 °C) to the flask using a serological pipette.
- a.
- 2 mL for a 25 cm2 flask.
- b.
- 3 mL for a 75 cm2 flask.
- 7.
- Incubate the flask at room temperature until most cells are rounded/dislodged by visualizing under a microscope (3–5 min).
- a.
- May require gentle to moderate rocking or gentle tapping of the flask to dislodge the cells.
- 8.
- Neutralize trypsin using the culture medium collected in step 3.
- a.
- 5 mL for a 25 cm2 flask.
- b.
- 9 mL for a 75 cm2 flask.
- 9.
- Using a 10 mL pipette, wash the cells from the flask by holding the flask at a 45° angle and pipetting (5–10 times) gently down the bottom of the flask.
- a.
CRITICAL STEP—Avoid excessive or rigorous pipetting, which may result in cell damage.
- b.
- The bottom of the flask should look clear against a light when all the cells have been washed off. Presence of a translucent layer/patches indicates the presence of cells that have not been washed off.
- 10.
- Transfer the suspension to a 50 mL centrifuge tube combining with the cell suspension collected in step 3.
- 11.
- Pellet down the cells by centrifuging for 5 min at 280× g, RT.
- a.
- A cell pellet should be visible.
- 12.
- Carefully discard the supernatant by pipetting or decanting.
- 13.
- Resuspend the pellet in 9 mL fresh complete medium and pipetting up and down to break down the large clumps.
- 14.
- In a 0.2 mL tube, count total and live cells, as explained in Section 3.1 step 6.
- 15.
- Calculate the volume of cell suspension required for a seeding density of 7.9 × 106 live cells.
- 16.
- Fill the 75 cm2 flask in an upright position with a total of 20 mL of culture medium less the amount of cell suspension calculated in step 15.
- 17.
- Add the volume of cell culture calculated in step 15 to the flask.
- 18.
- Tighten the cap if vented. Leave it slightly loose if not vented.
- 19.
- Rock the flasks in four directions (north-south, east-west) a few times before placing into the incubator.
- a.
CRITICAL STEP—Avoid swirling the flasks as that will result in the cells concentrating around the perimeter of the flask leading to uneven growth.
- 20.
- Incubate at 37 °C, 5% CO2 for 2 d.
- 21.
- After 2 d, repeat steps 1–2.
- 22.
- When removing the cell culture medium, discard instead of retaining.
- a.
- Note: we found that alternating keeping vs. discarding suspension cells in the old cell culture medium resulted in the best compromise between the number of adherent cells and total cell counts.
- b.
- When propagating MHV, the old cell culture medium is removed prior to the addition of the virus suspension. As a result, by discarding the old cell culture medium at this stage, the cell counts from this passage could be used to estimate MOI calculations.
- 23.
- Repeat steps 4–14.
- 24.
- Calculate a cell seeding density of 4.0 × 106 cells for a 75 cm2 flask.
- 25.
- Repeat steps 16–19.
- 26.
- Incubate at 37 °C, 5% CO2 for 5 d.
3.2.2. NCTC Clone 929 (72–96 h)
- 1.
- Temper PBS, trypsin, and complete EMEM to 37 °C in a water bath.
- 2.
- For each passage, prepare at least two flasks (one flask as a backup).
- 3.
- Once the cells reach 80–95% confluency (see Figure 1b), remove the culture medium by decanting or pipetting and discarding it in a waste container.
- 4.
- While holding the flask at a 45° angle, wash the cell monolayer by gently dispensing PBS (tempered to 37 °C) using a serological pipette to remove any residual serum that may interfere with trypsinization.
- a.
- Use 5 mL PBS for a 25 cm2 flask and 10 mL PBS for a 75 cm2 flask.
- b.
- Only wash once and avoid shaking to prevent dislodging cells.
- 5.
- Rotate the flask so that the wash PBS accumulates in the corner opposite the cell monolayer (normally one of the top corners) and remove using the same serological pipette.
- a.
- Discard the PBS wash into the waste container.
- i.
- Bleach the waste container before disposal.
- b.
CRITICAL STEP—Avoid touching the bottom of the flask with the pipette and accidentally scraping off cells.
- 6.
- Add trypsin (tempered to 37 °C) to the flask using a serological pipette.
- a.
- 2 mL for 25 cm2 flasks
- b.
- 3 mL for 75 cm2 flasks
- 7.
- Incubate the flask at room temperature until most cells are rounded by visualizing under a microscope (2–4 min).
- 8.
- Neutralize trypsin using fresh complete EMEM (tempered to 37 °C).
- a.
- 5 mL for a 25 cm2 flask
- b.
- 9 mL for a 75 cm2 flask
- 9.
- Using a 10 mL pipette, wash the cells from the flask by holding the flask at a 45° angle and pipetting (5–10 times) gently down the bottom of the flask.
- a.
CRITICAL STEP—Avoid excessive or rigorous pipetting, which may result in cell damage.
- b.
- The bottom of the flask should look clear against a light when all the cells have been washed off. Presence of a translucent layer/patches indicates the presence of cells that have not been washed off.
- 10.
- Transfer the suspension a 15 mL centrifuge tube.
- 11.
- Pellet down the cells by centrifuging for 5 min at 280× g, RT.
- a.
- A cell pellet should be clearly visible.
- 12.
- Carefully discard the supernatant by pipetting or decanting.
- 13.
- Resuspend the cells in 9 mL medium by pipetting up and down to break up the pellet and large clumps.
- 14.
- In a 0.2 mL tube, combine 10 µL of cell suspension with 10 µL trypan blue and mix gently by pipetting. Pipet 10 µL of the mixture into a cell counting slide then count the total and live cells.
- a.
- Ensure the cell counting slide is clean without any dust or fingerprints.
- b.
CRITICAL STEP—Ensure no air bubbles are trapped in the cell counting slide to obtain an accurate reading.
- 15.
- Calculate cell seeding densities for a 75 cm2 flask:
- a.
- For a passage after 72 h: 1.5 × 106 cells.
- b.
- For a passage after 96 h: 1.0 × 106 cells.
- c.
- Note: as the passage number increases, the cells will become more acclimated to laboratory conditions resulting in faster growth. As a result, the seeding density may need to be decreased to ensure the monolayer does not become too dense. NCTC clone 929 is sensitive to high density with the cells first turning rounded then sloughing off. Initially, the round cells are still alive, but viability will decrease soon after.
- d.
- It is recommended to always run a backup flask with 1:10 seeding density.
- 16.
- Fill the 75 cm2 flask in an upright position for a total of 20 mL of medium less the amount of cell suspension calculated in step 15.
- 17.
- Add the volume of cell culture calculated in step 15 to the flask.
- 18.
- Tighten the cap if vented. Leave it slightly loose if not vented.
- 19.
- Rock the flasks in four directions (north-south, east-west) a few times before placing into the incubator.
- a.
CRITICAL STEP—Avoid swirling the flasks as this will result in the cells concentrating around the perimeter of the flask leading to uneven growth.
- 20.
- Incubate at 37 °C, 5% CO2 for 3–4 d or until confluency reaches 80–95%.
3.3. Cryopreservation (24 h)
- 1.
- Grow cells until at least 0.5 × 106 cells/mL with >90% viability is reached (passage 4 to 7).
- 2.
- Proceed with cell passage steps 3–12 as described in Section 3.2.1 for NCTC clone 1469 or Section 3.2.2 for NCTC clone 929.
- 3.
- Resuspend the cells using 9 mL of cold (ca. 4 °C) freezing medium and pipette up and down to break clumps.
- a.
- DMEM freezing medium for NCTC clone 1469
- b.
- EMEM freezing medium for NCTC clone 929
- 4.
- Perform cell count as explained above.
- 5.
- Adjust the cell density to ca. 1.0 × 106 live cells/mL.
- 6.
- Using a 10 mL serological pipette, add 1 mL cell suspension to each 2 mL cryogenic vial.
- a.
- Ensure to screw caps tight.
- 7.
- Place tubes into Nalgene Mr. Frosty freezing container after preparing container using manufacturer’s instructions. Then place Mr. frosty container into the −80 °C freezer for 24 h.
- 8.
- After 24 h, transfer cryogenic vials to nitrogen vapor phase for long-term storage.
- 9.
- After a few days, revive one of the frozen cell vials to ensure cell viability.
3.4. MHV Propagation
3.4.1. Infection of Cells (68.5–70.5 h)
- 1.
- Passage NCTC clone 1469 cells into a 75 cm2 flask at a seeding density of 7.0 × 106 live cells using complete DMEM.
- a.
- 48 h later, the flask should be 60–80% confluent.
- 2.
- Temper base and complete NCTC-135 medium to 37 °C.
- 3.
- Thaw a vial of MHV-A59 (ATCC VR-764) in a 37 °C water bath (it takes ca. 3 min).
- 4.
- Prepare dilutions of the virus in a 15 mL centrifuge tube using base NCTC-135 medium (final volume 2.5 mL for a 75 cm2 flask) for the desired MOI.
- a.
- We found that an MOI between 7 × 10−4 and 3 × 10−5 produced an optimum viral titer.
- i.
- See Table 1 for example MOI’s and titers of virus produced.
- b.
- When using the original frozen stock, the ATCC recommends [32]:
- i.
- For titer between 3–6 log TCID50, dilute virus 1:100 before inoculation.
- ii.
- For titer greater than 6 log TCID50, dilute virus 1:1000 before inoculation.
- 5.
- Remove cell culture medium from flask and add 2.5 mL of the diluted virus inoculum.
- a.
- Gently rock forward and backward to distribute evenly.
- 6.
- Incubate flask at 37 °C, 5% CO2 for 1 h.
- a.
- Gently rock flask forward and backward every 15 min.
- b.
- Ideally, this would be in an incubator separate from the one used for normal cell culture to prevent accidental viral contamination.
- 7.
- After 1 h, remove the virus inoculum and add 20 mL of complete NCTC-135 medium (5% Horse Serum).
- 8.
- Place the flask back in the incubator (37 °C, 5% CO2) for 18–20 h until the cytopathic effects (CPE) become visible.
- 9.
- CPE for this virus is the formation of syncytium: fusion of cells into large, multinucleate cells. These will be detached from the flask and floating in suspension.
3.4.2. Harvesting MHV (3 h)
- 1.
AUSE STEP—When 90% of cells exhibit cytopathic effects (see Figure 2), roughly 18–20 h post-infection, move the flask to the −80 °C freezer.
- a.
- The frozen flask can be stored until a later date before proceeding to the rest of the steps.
- 2.
- After the flask has frozen (at least 30 min), move the flask immediately into a large water bath at 37 °C.
- a.
CRITICAL STEP—Avoid submerging the cap.
- 3.
- Allow to thaw for ca. 10 min, then remove and vigorously shake the flask for ca. 30 s to help lyse the cells.
- 4.
CRITICAL STEP—De-gas the flask in the biosafety cabinet by briefly opening the cap to prevent any occasional pressure buildup during the freeze-thaw.
- 5.
- Place the flask back into the −80 °C freezer for at least 30 min.
- 6.
- Repeat steps 2–5 two more times.
- 7.
- Following the third freeze-thaw cycle, collect as much as the cell culture lysate as possible using a serological pipette moving it into a 50 mL centrifuge tube.
- 8.
- Centrifuge the tube at 12,000× g for 20 min at 18 °C.
- 9.
- Carefully decant the supernatant into a new centrifuge tube.
- a.
- OPTIONAL STEP—After centrifuging, pass virus supernatant through a 0.2 µm filter to further remove the debris.
- 10.
- Quick freeze the vials by placing them into the liquid nitrogen storage vessel for ca. 30 min before moving to the −80 °C freezer for long-term storage.
3.5. MHV Plaque Assay
3.5.1. NCTC Clone 929 Cell Preparation (24 h)
- 1.
- Follow the NCTC clone 929 passage protocol (3.2.2) to harvest the cells from the flask (steps 1–14).
- 2.
- Add 9.5 × 105 NCTC clone 929 cells per well into a 6-well plate with a total volume of 2.5 mL.
- 3.
- Rock the plates in four directions (north-south, east-west) to ensure the distribution of the cells.
- a.
CRITICAL STEP—Avoid swirling the plates as this will result in the cells concentrating around the perimeter of the well leading to uneven growth.
- 4.
- Incubate the plates for 24 h at 37 °C, 5% CO2 at which point there should reach >90% confluency.
- a.
- Note: there are two methods that can be used at this point to set up an MHV plaque assay. In Section 3.5.2, a solid agarose overlay is applied after MHV infection of the cells followed by Section 3.5.3 to stain the cells using Neutral Red dye. Alternatively, Section 3.5.4 employs a methyl cellulose overlay followed by Section 3.5.5 to fix and stain the cells using formaldehyde with crystal violet. See 4. Expected results for discussion of the two approaches.
3.5.2. NCTC Clone 929 Infection with MHV Using a Solid Overlay (48 h)
- 1.
- Once the cells are >90% confluent, thaw an MHV virus aliquot in a water bath at 37 °C (ca. 2–3 min).
- 2.
- Prepare serial dilutions of the virus in base NCTC-135 medium.
- 3.
- Move the 6-well plates to the infectious biosafety hood and aspirate the cell culture medium into a waste container.
- a.
CRITICAL STEP—Work with up to three 6-well plates at a time to prevent the cell monolayer from drying out.
- 4.
- Gently add 500 µL of the virus suspension to each well. Ensure the pipette tip touches the inside wall of each well.
- 5.
- Rock the plate in four directions (north-south, east-west) to ensure the virus suspension covers the monolayer.
- 6.
- Incubate the plates for an hour in the incubator (37 °C, 5% CO2), rocking the cells gently every 15 min to distribute the virus evenly.
- 7.
- While the plates are incubating, prepare the overlay by melting 3% SeaPlaque™ agarose then tempering to 39–42 °C along with 2 × Plaque Assay Medium in a water bath.
- a.
- Once both are tempered, combine in a 1:1 ratio depending on the number of plaque assay plates. You will need 2.5 mL per well or 15 mL per 6-well plate.
- b.
CRITICAL STEP—Ensure that the melted agarose has cooled to 39–42 °C before combining with the plaque assay medium.
- 8.
- Gently add 2.5 mL of the above overlay to each well.
- 9.
- Leave plates in the biosafety cabinet for ca. 15 min until the agarose solidifies.
- 10.
- Place the plates in the incubator (37 °C, 5% CO2) for 48 h until the plaques are visible.
3.5.3. Staining plaque assay plates with solid overlay (2.5–4.5 h)
- Once plaques are faintly visible (roughly 48 h after infection), prepare 0.04% v/v Neutral Red in PBS (pH 7.2).
- Stain the wells by adding 1 mL of 0.04% Neutral Red to each.
- Place the plates back into the incubator (37 °C, 5% CO2) for 2–4 h.
- Remove the neutral red stain.
- Flip over the plate and count the plaques per well (see Figure 3a).
- Virus titer is calculated using the following Equation (1):
3.5.4. ALTERNATIVE: NCTC Clone 929 Infection with MHV Using a Methyl Cellulose Overlay Solution (48 h)
- 1.
- Prepare 0.8% Methyl Cellulose overlay medium by combining a 1.6% w/v methyl cellulose solution and 2× Plaque Assay medium in a 1:1 ratio and temper to 37 °C in a water bath (see Section 5.2.5 for details).
- 2.
- Follow steps 1–6 from Section 3.5.2.
- 3.
- Gently add 2.5 mL of the methyl cellulose overlay medium.
- 4.
- Place the plates in the incubator (37 °C, 5% CO2) for 48 h until the plaques are visible.
- a.
- Avoid moving the plates during the incubation period and disrupting the fluid overlay.
3.5.5. ALTERNATIVE: Fixing and Staining Plaque Assay Plates Overlayed with Methyl Cellulose (2.5–4.5 h)
- 1.
- Once plaques are faintly visible (roughly 48 h after infection), prepare fresh fixing/staining solution (see Section 5.2.6 details).
- a.
CRITICAL STEP—Keep this solution in the dark until ready for use.
- 2.
- In a fume hood, remove the methyl cellulose overlay using a serological pipette and add 1 mL of the above formaldehyde-crystal violet fixing/staining solution.
- 3.
- Leave the plates in the fume hood for 2–4 h.
- 4.
- Aspirate the fixing/staining solution.
- 5.
- Gently rinse the wells using tap water until the rinsate runs clear.
- 6.
- Flip over the plate and count the plaques per well (see Figure 3b).
- 7.
- Calculate titer using Equation (1) from Section 3.5.3.
4. Expected Results
5. Reagents Setup
5.1. Cell Culture Media
5.1.1. DMEM Complete Medium for NCTC Clone 1469, 500 mL
- 6.74 g DMEM powder (Corning #50-003-PB).
- 10 mL 7.5% Sodium Bicarbonate (Gibco #25080094)—for a final concentration of 1.5 g/L.
- 490 mL Cell Culture Grade Water (or autoclaved deionized water).
- Filter-sterilize the above base medium using a 0.2 µm vacuum filter, replace 55 mL of the medium with:
- ○
- 5.0 mL 100× Penicillin-Streptomycin (Gibco #15140-122).
- ○
- 50.0 mL Horse Serum (Gibco #16050-122)—for a final concentration of 10%.
5.1.2. Complete EMEM for NCTC Clone 929, 500 mL
- 4.8 g EMEM powder (Sigma #M0643).
- 14.7 mL 7.5% Sodium Bicarbonate (Gibco #25080094).
- 5.0 mL 100 mM Sodium Pyruvate (Sigma #S8636).
- 480.3 mL Cell Culture Grade Water (or autoclaved deionized water).
- Filter-sterilize the above base medium using a 0.2 µm PES vacuum filter, replace 55 mL of the medium with:
- ○
- 5.0 mL 100× Penicillin-Streptomycin (Gibco #15140-122).
- ○
- 50.0 mL Horse Serum (Gibco #16050-122) for a final concentration of 10%.
5.1.3. Cell Freezing Medium, 50 mL
- To 42.275 mL of base medium removed above (DMEM for NCTC clone 1469, EMEM for NCTC clone 929), add 2.5 mL of DMSO (Sigma #D4540-100ML). Filter-sterilize using a 0.2 µm vacuum filter, then add the following to make complete:
- ○
- 0.475 mL 100× Penicillin-Streptomycin (Gibco #15140-122).
- ○
- 4.75 mL Horse Serum (Gibco #16050-122).
5.1.4. NCTC-135 Medium for MHV Propagation, 500 mL
- 4.7 g NCTC-135 powder (Sigma # N3262).
- 14.7 mL 7.5% Sodium Bicarbonate—for a final concentration of 2.2 g/L (Gibco #25080094).
- 485.3 mL Cell Culture Grade Water (or autoclaved deionized water).
- Filter-sterilize the above base medium using a 0.2 µm PES vacuum filter. To prepare NCTC-135 medium with 5% Horse Serum (100 mL), combine 95 mL of the filter-sterilized NCTC-135 base medium with 5 mL Horse Serum (Gibco #16050-122).
5.2. Plaque Assay Media and Reagents
5.2.1. 2× EMEM for Plaque Assay, 500 mL
- 9.6 g EMEM powder (Sigma #M0643).
- 29.4 mL 7.5% Sodium Bicarbonate (Gibco #25080094).
- 10.0 mL 100 mM Sodium Pyruvate (Sigma #S8636).
- 460.6 mL Cell Culture Grade Water (or autoclaved deionized water).
- Filter-sterilize the above base medium using a 0.2 µm PES vacuum filter, replace 30 mL of the medium with:
- ○
- 10.0 mL 100× Penicillin-Streptomycin (Gibco #15140-122).
- ○
- 20.0 mL Horse Serum—for a final concentration of 4% (Gibco #16050-122).
5.2.2. 3% SeaPlaque Agarose, 500 mL
- 15 g SeaPlaque Agarose (Lonza #50100).
- 500 mL deionized water.
- Autoclave to sterilize and store at room temperature. Prior to use in a plaque assay, melt using a microwave or in hot water. Can also aliquot the autoclaved agarose into 5 sterile 100 mL bottles.
5.2.3. 1% Neutral Red, 100 mL
- 1 g Neutral Red (ACROS #229811000).
- 100 mL PBS, pH 7.2 (Gibco #20012-027).
- Dissolve then filter-sterilize using a 0.2 µm vacuum filter. Store in the dark.
5.2.4. 1.6% Methyl Cellulose, 250 mL
- 4 g Methyl cellulose, viscosity 4000 cP (Sigma M0512).
- 250 mL DI water.
- Autoclave the methyl cellulose powder in a 500 mL bottle with a stir bar. Autoclave the water separately in another bottle. When the water has cooled enough to handle safely (roughly 50–60 °C), add 250 mL of the water to the methyl cellulose. Place on a stir plate at room temperature for 5 min, then move the bottle and stir plate into a refrigerator or incubator set to 4–6 °C. Stir 2–4 h or until the solution is clear; store refrigerated.
5.2.5. 0.8% Methyl Cellulose Overlay Medium, 500 mL
- To the 250 mL of 1.6% Methyl Cellulose from Section 5.2.4, add 250 mL of 2× medium for plaque assay from Section 5.2.1 in a biosafety cabinet. Stir to mix well.
5.2.6. Fixing/Staining Solution, 100 mL
- 10 mL Formaldehyde, 37% by Weight (Fisher BioReagents #BP531-500).
- 10 mL Crystal Violet, 1% aqueous solution (Sigma-Aldrich #V5265).
- 80 mL DI water.
- Prepare in a fume hood and store in the dark until use.
Author Contributions
Funding
Institutional Review Board Statement
Informed Consent Statement
Data Availability Statement
Conflicts of Interest
References
- Monto, A.S. Medical reviews. Coronaviruses. Yale J. Biol. Med. 1974, 47, 234. [Google Scholar]
- Snijder, E.J.; Bredenbeek, P.J.; Dobbe, J.C.; Thiel, V.; Ziebuhr, J.; Poon, L.L.; Guan, Y.; Rozanov, M.; Spaan, W.J.; Gorbalenya, A.E. Unique and conserved features of genome and proteome of SARS-coronavirus, an early split-off from the coronavirus group 2 lineage. J. Mol. Biol. 2003, 331, 991–1004. [Google Scholar] [CrossRef]
- Hilgenfeld, R.; Peiris, M. From SARS to MERS: 10 years of research on highly pathogenic human coronaviruses. Antivir. Res. 2013, 100, 286–295. [Google Scholar] [CrossRef]
- Peiris, J.; Lai, S.; Poon, L.; Guan, Y.; Yam, L.; Lim, W.; Nicholls, J.; Yee, W.; Yan, W.; Cheung, M. Coronavirus as a possible cause of severe acute respiratory syndrome. Lancet 2003, 361, 1319–1325. [Google Scholar] [CrossRef] [Green Version]
- WHO MERS-CoV Research Group. State of knowledge and data gaps of Middle East respiratory syndrome coronavirus (MERS-CoV) in humans. PLoS Curr. 2013, 5. [Google Scholar] [CrossRef]
- World Health Organization (WHO). MERS Situation Update—December 2018. Available online: https://applications.emro.who.int/docs/EMROPub_2018_EN_20792.pdf?ua=1 (accessed on 22 November 2021).
- Zumla, A.; Hui, D.S.; Perlman, S. Middle East respiratory syndrome. Lancet 2015, 386, 995–1007. [Google Scholar] [CrossRef] [Green Version]
- Martellucci, C.A.; Flacco, M.E.; Cappadona, R.; Bravi, F.; Mantovani, L.; Manzoli, L. SARS-CoV-2 pandemic: An overview. Adv. Biol. Regul. 2020, 77, 100736. [Google Scholar] [CrossRef]
- World Health Organization (WHO). WHO Coronavirus (COVID-19) Dashboard. Available online: https://covid19.who.int/ (accessed on 13 October 2021).
- Ranard, B.L.; Megjhani, M.; Terilli, K.; Doyle, K.; Claassen, J.; Pinsky, M.R.; Clermont, G.; Vodovotz, Y.; Asgari, S.; Park, S. Identification of endotypes of hospitalized COVID-19 patients. Front. Med. 2021, 8, 770343. [Google Scholar] [CrossRef]
- Bajgain, K.T.; Badal, S.; Bajgain, B.B.; Santana, M.J. Prevalence of comorbidities among individuals with COVID-19: A rapid review of current literature. Am. J. Infect. Control 2021, 49, 238–246. [Google Scholar] [CrossRef]
- Kaufer, A.M.; Theis, T.; Lau, K.A.; Gray, J.L.; Rawlinson, W.D. Laboratory biosafety measures involving SARS-CoV-2 and the classification as a Risk Group 3 biological agent. Pathology 2020, 52, 790–795. [Google Scholar] [CrossRef]
- U.S. Department of Health and Human Services (U.S. HSS). Biosafety in Microbiological and Biomedical Laboratories; US Department of Health and Human Services: Washington, DC, USA, 2009.
- ASTM International. Guidance on SARS-CoV-2 Surrogate Selection. Available online: https://sn.astm.org/?q=features/surrogates-and-fight-against-covid-19-.html (accessed on 19 October 2021).
- Perlman, S. Pathogenesis of coronavirus-induced infections. In Coronaviruses and Arteriviruses: Review of Pathological and Immunological Aspects; Plenum Press: New York, NY, USA, 1998; pp. 503–513. [Google Scholar]
- Weiss, S.R.; Navas-Martin, S. Coronavirus pathogenesis and the emerging pathogen severe acute respiratory syndrome coronavirus. Microbiol. Mol. Biol. Rev. 2005, 69, 635–664. [Google Scholar] [CrossRef] [Green Version]
- Weiner, L.P. Pathogenesis of demyelination induced by a mouse hepatitis. Arch. Neurol. 1973, 28, 298–303. [Google Scholar] [CrossRef]
- Macphee, P.J.; Dindzans, V.J.; Fung, L.S.; Levy, G.A. Acute and chronic changes in the microcirculation of the liver in inbred strains of mice following infection with mouse hepatitis virus type 3. Hepatology 1985, 5, 649–660. [Google Scholar] [CrossRef]
- Homberger, F.R. Enterotropic mouse hepatitis virus. Lab. Anim. 1997, 31, 97–115. [Google Scholar] [CrossRef] [Green Version]
- Graham, R.L.; Donaldson, E.F.; Baric, R.S. A decade after SARS: Strategies for controlling emerging coronaviruses. Nat. Rev. Microbiol. 2013, 11, 836–848. [Google Scholar] [CrossRef] [Green Version]
- Li, X.; Chang, J.; Chen, S.; Wang, L.; Yau, T.O.; Zhao, Q.; Hong, Z.; Ruan, J.; Duan, G.; Gao, S. Genomic feature analysis of betacoronavirus provides insights into SARS and COVID-19 pandemics. Front. Microbiol. 2021, 12, 614494. [Google Scholar] [CrossRef]
- Fehr, A.R.; Perlman, S. Coronaviruses: An overview of their replication and pathogenesis. In Coronaviruses: Methods and Protocols; Humana Press: New York, NY, USA, 2015; pp. 1–23. [Google Scholar]
- Fan, X.; Cao, D.; Kong, L.; Zhang, X. Cryo-EM analysis of the post-fusion structure of the SARS-CoV spike glycoprotein. Nat. Commun. 2020, 11, 3618. [Google Scholar] [CrossRef]
- Casanova, L.M.; Jeon, S.; Rutala, W.A.; Weber, D.J.; Sobsey, M.D. Effects of air temperature and relative humidity on coronavirus survival on surfaces. Appl. Environ. Microbiol. 2010, 76, 2712–2717. [Google Scholar] [CrossRef] [Green Version]
- Dellanno, C.; Vega, Q.; Boesenberg, D. The antiviral action of common household disinfectants and antiseptics against murine hepatitis virus, a potential surrogate for SARS coronavirus. Am. J. Infect. Control 2009, 37, 649–652. [Google Scholar] [CrossRef] [Green Version]
- Agostini, M.L.; Andres, E.L.; Sims, A.C.; Graham, R.L.; Sheahan, T.P.; Lu, X.; Smith, E.C.; Case, J.B.; Feng, J.Y.; Jordan, R. Coronavirus susceptibility to the antiviral remdesivir (GS-5734) is mediated by the viral polymerase and the proofreading exoribonuclease. mBio 2018, 9, e00221-18. [Google Scholar] [CrossRef] [Green Version]
- De Wilde, A.H.; Falzarano, D.; Zevenhoven-Dobbe, J.C.; Beugeling, C.; Fett, C.; Martellaro, C.; Posthuma, C.C.; Feldmann, H.; Perlman, S.; Snijder, E.J. Alisporivir inhibits MERS-and SARS-coronavirus replication in cell culture, but not SARS-coronavirus infection in a mouse model. Virus Res. 2017, 228, 7–13. [Google Scholar] [CrossRef] [Green Version]
- Leibowitz, J.; Kaufman, G.; Liu, P. Coronaviruses: Propagation, quantification, storage, and construction of recombinant mouse hepatitis virus. Curr. Protoc. Microbiol. 2011, 21, 15E.11.11–15E.11.46. [Google Scholar] [CrossRef]
- Smither, S.J.; Lear-Rooney, C.; Biggins, J.; Pettitt, J.; Lever, M.S.; Olinger, G.G., Jr. Comparison of the plaque assay and 50% tissue culture infectious dose assay as methods for measuring filovirus infectivity. J. Virol. Methods 2013, 193, 565–571. [Google Scholar] [CrossRef]
- Cervantes-Barragán, L.; Kalinke, U.; Züst, R.; König, M.; Reizis, B.; López-Macías, C.; Thiel, V.; Ludewig, B. Type I IFN-mediated protection of macrophages and dendritic cells secures control of murine coronavirus infection. J. Immunol. 2009, 182, 1099–1106. [Google Scholar] [CrossRef] [Green Version]
- Kindler, E.; Gil-Cruz, C.; Spanier, J.; Li, Y.; Wilhelm, J.; Rabouw, H.H.; Züst, R.; Hwang, M.; V’kovski, P.; Stalder, H.; et al. Early endonuclease-mediated evasion of RNA sensing ensures efficient coronavirus replication. PLoS Pathog. 2017, 13, e1006195. [Google Scholar] [CrossRef]
- American Type Culture Collection (ATCC). What Are the General Guidelines for Growing a Virus in Tissue Culture? Available online: https://www.atcc.org/support/technical-support/faqs/growing-viruses-in-adherent-tissue-culture (accessed on 28 September 2021).

| MOI | Avg. Titer (Log PFU/mL) |
|---|---|
| 3 × 10−2 | 5.67 |
| 3 × 10−3 | 6.20 |
| 7 × 10−4 | 6.43 |
| 3 × 10−5 | 6.43 |
Publisher’s Note: MDPI stays neutral with regard to jurisdictional claims in published maps and institutional affiliations. |
© 2022 by the authors. Licensee MDPI, Basel, Switzerland. This article is an open access article distributed under the terms and conditions of the Creative Commons Attribution (CC BY) license (https://creativecommons.org/licenses/by/4.0/).
Share and Cite
Shuipys, T.; Montazeri, N. Optimized Protocols for the Propagation and Quantification of Infectious Murine Hepatitis Virus (MHV-A59) Using NCTC Clone 1469 and 929 Cells. Methods Protoc. 2022, 5, 5. https://doi.org/10.3390/mps5010005
Shuipys T, Montazeri N. Optimized Protocols for the Propagation and Quantification of Infectious Murine Hepatitis Virus (MHV-A59) Using NCTC Clone 1469 and 929 Cells. Methods and Protocols. 2022; 5(1):5. https://doi.org/10.3390/mps5010005
Chicago/Turabian StyleShuipys, Tautvydas, and Naim Montazeri. 2022. "Optimized Protocols for the Propagation and Quantification of Infectious Murine Hepatitis Virus (MHV-A59) Using NCTC Clone 1469 and 929 Cells" Methods and Protocols 5, no. 1: 5. https://doi.org/10.3390/mps5010005
APA StyleShuipys, T., & Montazeri, N. (2022). Optimized Protocols for the Propagation and Quantification of Infectious Murine Hepatitis Virus (MHV-A59) Using NCTC Clone 1469 and 929 Cells. Methods and Protocols, 5(1), 5. https://doi.org/10.3390/mps5010005



